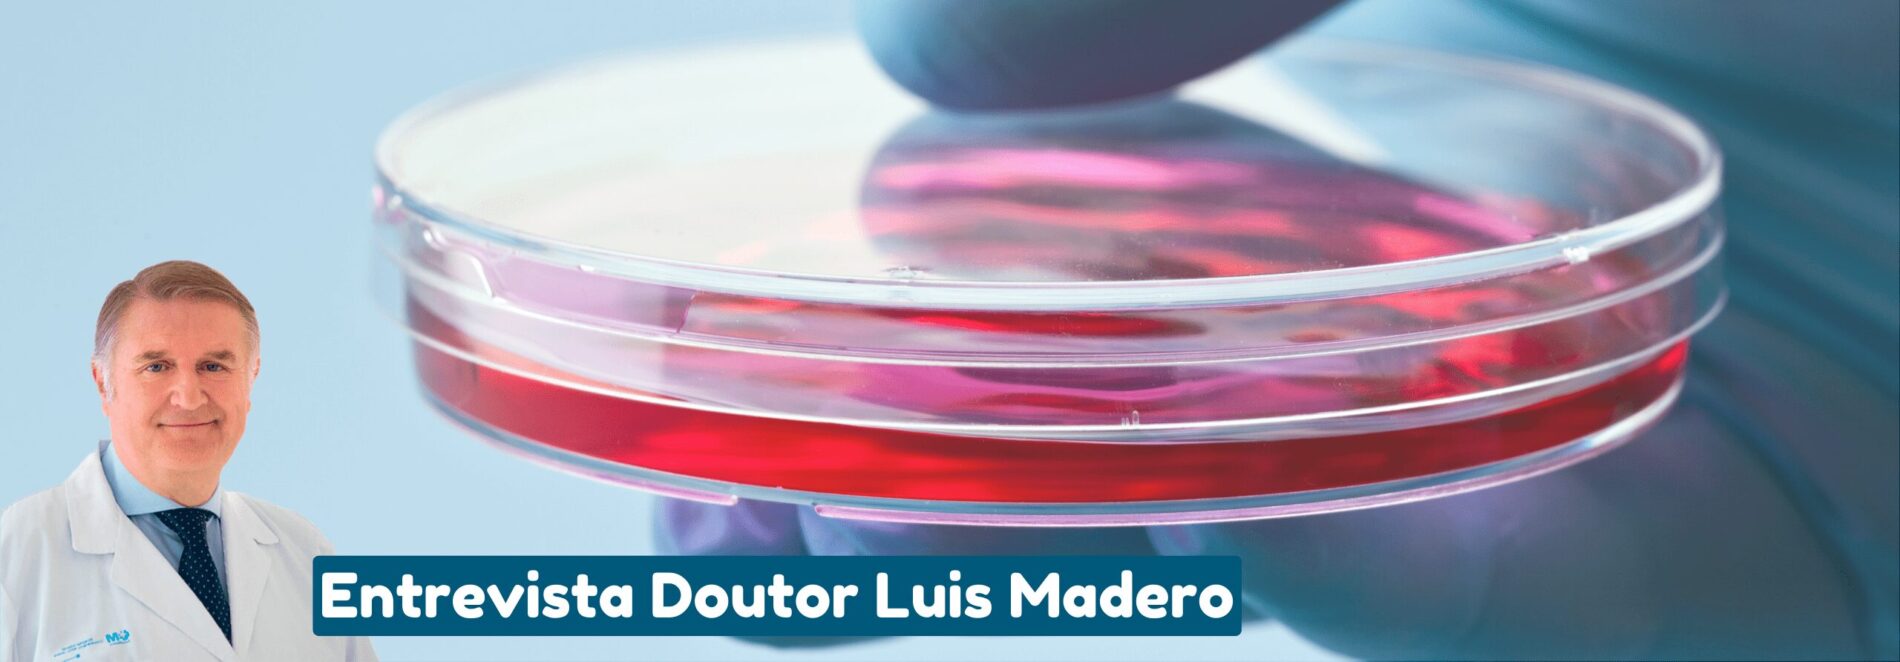
O potencial terapêutico e o futuro do transplante de sangue do cordão umbilical - 99

Em 1988, um acontecimento mudaria para sempre a forma como olhávamos para o nosso corpo e para o momento do nascimento: um transplante de células estaminais do sangue do cordão umbilical, realizado pela Dr.ª Eliane Gluckman, em França, que salvou a vida de um menino que lutava contra a Anemia de Fanconi. Desde então, há já 34 anos, médicos em todo o mundo começaram a explorar as possibilidades de usar esta nova fonte de células estaminais não controversas. Todos os dias, em várias partes do mundo realizam-se transplantes de células estaminais com origem no sangue do cordão umbilical. Para discutir os avanços mais significativos até hoje e as perspetivas futuras mais promissoras das terapias com células estaminais, a News Farma entrevistou o Prof. Doutor Luis Madero, responsável pelo Serviço de Hemato-Oncologia Pediátrica no Hospital Quirónsalud-Madrid e consultor científico da BebéVida.
Publicações Relacionadas
Tratamento da Paralisia Cerebral com células estaminais do cordão umbilical releva-se cada vez mais promissor
A propósito do Dia Mundial da Paralisia Cerebral, assinalado a 6 de outubro, a BebéVida destaca as mais recentes evidências... Leia mais
Transplante com Células Estaminais em doentes com Covid-19
Transplante com células estaminais mesenquimais melhora a condição dos pacientes com pneumonia devido a infeção por Covid-19Foi levado a cabo... Leia mais
Tratamento da córnea de 14 pacientes através das células estaminais dos seus próprios olhos
Um ensaio clínico expandido em fase 1-2, está a trazer ótimas notícias ao mundo da oftalmologia e esperança para as... Leia mais
Novo estudo sobre o cancro da mama com células do cordão umbilical modificadas
Cientistas desenvolveram uma nova terapia celular para o cancro da mama triplo-negativo, um dos tipos mais agressivos e difíceis de... Leia mais
Imunoterapia e o uso do Sangue do Cordão
Há um optimismo na comunidade do sangue do cordão umbilical de que as unidades de sangue do cordão umbilical podem... Leia mais
Resgate do sangue do cordão umbilical após paragem cardíaca
Esta é a história de um menino que sofreu uma paragem cardíaca prolongada e que foi reanimado, permanecendo em estado... Leia mais
BebéVida celebra 15 anosBebéVida celebra 15 anos com a presença de muitas caras conhecidas
No passado dia 18 de outubro, a BebéVida celebrou o seu 15.º aniversário, nas instalações do laboratório de células estaminais,... Leia mais
Campanha solidária da BebéVida apoia IPO-Porto
Até 31 de maio, por cada pack de Mascotes Solidárias vendido, a BebéVida doará 5€ à Ala Pediátrica do IPO-Porto.Para... Leia mais
Nova terapia celular para lesões crónicas da medula espinal
O Hospital Puerta de Hierro, em Madrid, iniciou o tratamento de pacientes com terapia celular denominada NC1. Esta terapia experimental, pioneira na Europa, está... Leia mais
BebéVida: de PME Líder a PME ExcelênciaDe PME Líder a PME Excelência
Após 6 anos consecutivos como PME Líder, o Laboratório BebéVida recebeu este ano a distinção PME Excelência.Para a equipa BebéVida... Leia mais